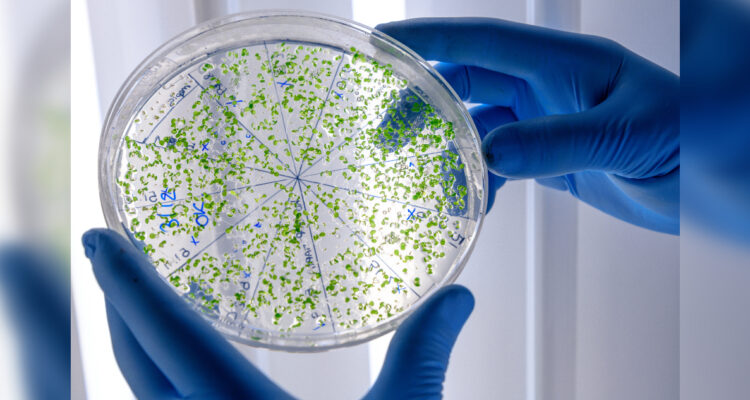
superbacterias

Las superbacterias, microorganismos resistentes a la mayoría de los medicamentos, se han convertido en las últimas décadas en una de las preocupaciones del mundo científico debido a la los potenciales riesgos que pueden provocar estos microbios.
La comunidad científica lleva años estudiando las superbacterias -microorganismos resistentes a un gran número de medicamentos- y los peligros que esconden para el ser humano. Incluso, se han detectado que algunos antibióticos perdieron su efectividad ante algunas de estas bacterias.
De acuerdo con un estudio publicado este año por la revista The Lancet, el escenario ha empeorado, ya que las infecciones provocadas por estos microbios han causado la muerte de aproximadamente 1,2 millones personas en 2019.
Del total de los decesos, cerca de 90 mil se registraron en América Latina. En conversaciones con el medio alemán Deutsche Welle, el microbiólogo Christian Trigoso mencionó que “ningún país del planeta está libre del problema de la multirresistencia antibiótica”.
El jefe del Laboratorio de Referencia en Bacteriología Clínica del Instituto Nacional de Laboratorios de Salud (Inlasa), apuntó que “en un mundo donde las distancias físicas ya no representan un problema, los microorganismos en general se transportan ‘en’ y ‘con’ nosotros de una latitud a otra”.
Superbacterias: un enemigo silencioso
En las últimas décadas, el número de aislamientos bacterianos reportados, con métodos que buscan estudiar y desarrollar tratamientos efectivos contra los diferentes patógenos microbianos, se ha cuatriplicado con creces en Latinoamérica.
Esta situación da una idea de la magnitud del problema, pero también de las medidas emprendidas en la región para enfrentarlo, ya que conocer al enemigo es fundamental para combatirlo.
Se trata de un esfuerzo conjunto, coordinado por la Red Latinoamericana de Vigilancia de la Resistencia Antimicrobiana (Relavra), con el apoyo de la Organización Panamericana de la Salud (OPS).
Desde finales de los noventa, se han desarrollado una serie laboratorios de referencia nacional en prácticamente todos los países de Latinoamérica. “Los aislamientos bacterianos, obviamente, se hicieron mucho más visibles y la ventaja de contar con procedimientos técnicos uniformados y normalizados permiten lograr la comparación de lo que viene sucediendo en la región”, dijo el doctor Trigoso.
¿Una nueva pandemia?
Sin embargo, la situación dista de estar bajo control, en gran parte por la falta general de concienciación entre la gente.
“No hemos podido decodificar el lenguaje científico para que los mensajes puedan ser entendidos por la población. Tampoco se han logrado, desde la Academia, estrategias que puedan enfocarse hacia los futuros profesionales del área de la salud. Los vacíos en educación e información son dramáticos”, subrayó Trigoso.
La pandemia de covid-19 no ha mejorado la situación, ya que la prescripción excesiva o inadecuada de antimicrobianos facilita el desarrollo de bacterias resistentes y reduce la eficacia de futuros tratamientos. “La pandemia desnudó la debilidad de la respuesta inmediata desde los sectores de salud”, apuntó Christian Trigoso.
“El uso desmedido de antibióticos ha aumentado la carga de la resistencia bacteriana de estas moléculas. Recién estamos empezando a evidenciar estos alcances, precisamente a través de los mecanismos de vigilancia epidemiológica con los que cuentan los países de la región”, agregó el experto.
¿Camino a una panrresistentes?
Según los expertos, para el año 2050, las “superbacterias” matarán anualmente a 10 millones de seres humanos.
“Hay una necesidad urgente de aumentar la inversión en investigación y desarrollo, para luchar contra las infecciones resistentes a los antibióticos, entre ellas, la tuberculosis”, advirtió, en enero de 2022, Tedros Adhanom Ghebreyesus, director general de la Organización Mundial de la Salud.
“De otro modo, volveremos a los tiempos en los que la gente temía contraer infecciones habituales y ponía en riesgo su vida si se sometía a intervenciones quirúrgicas sencillas”, añadió.







 Enviando corrección, espere un momento...
Enviando corrección, espere un momento...